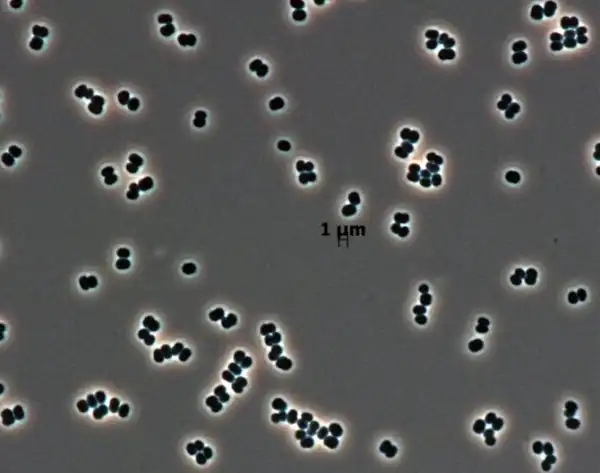

Международным комитетом таксономистов была названа десятка самых интересных видов живых организмов, обнаруженных за последний год.
Ежегодно, начиная с 2008 года, в день рождения великого шведского ученого Карла Линнея, создателя единой системы классификации растительного и животного мира, объявляется список самых интересных биологических видов, открытых в течение последнего года.
Олингито
Звездой этого списка по праву можно назвать олингито (Bassaricyon neblina), живущего в Эквадоре.
Речь идет о первом хищном млекопитающем, открытом за последние 35 лет в Новом Свете.
Помимо научной важности такого открытия, внешний вид зверька, напоминающего плюшевую игрушку, произвел настоящий фурор среди любителей животных.
Драконово дерево Кавесака
Прекрасное драконово дерево Кавесака (Dracaena kaweesakii) было идентифицировано как новый биологический вид лишь в прошлом году.
Если двадцатиметровое дерево, произрастающее в Таиланде, так долго оставалось незамеченным наукой, то, возможно, еще немало интересных видов на территории этой страны ждут своих первооткрывателей.
Актиния ANDRILL
Этот вид антарктических актиний был назван в честь Антарктической программы бурения (Antarctic Geological Drilling Program, ANDRILL). Это первый и пока единственный вид актиний, обитающих во льду.
Эти существа длиной в 2-3 сантиметра зарываются в ледяной шельф, оставляя снаружи в воде лишь пару десятков щупалец. Открытие сложных организмов, выживающих в столь суровых условиях, в прошлом году поразило зоологов.
Креветка-скелет
Новооткрытая креветка-скелет (Liropus minusculus) похожа на сказочное существо и, безусловно, является одним из красивейших и интереснейших видов беспозвоночных.
Обнаружили ее в пещере на острове Санта Каталина, неподалеку от Южной Калифорнии. Размер самки составляет примерно 2,5 мм, а самца - 3 мм.
Оранжевый пеницилл
Плесневой грибок оранжевый пеницилл (Penicillium vanoranjei), отличающийся ярким цветом, был назван так не только из-за своей окраски, но и в честь короля Нидерландов, принца Оранского.
Помимо цвета новый грибок интересен тем, что производит листовую структуру, которая защищает его от засыхания.
Листохвостый геккон
Листохвостого геккона (Saltuarius eximius), обитателя Австралии, обнаружить весьма непросто из-за его окраски-камуфляжа, а также необычно широкого хвоста в форме листа дерева.
Найти его можно в тропических лесах и скалах. Застыв в вертикальном положении на дереве или на камне, этот ночной охотник спокойно ждет, когда очередное неосторожное насекомое подберется поближе.
Исследователям не удалось обнаружить таких ящериц в близлежащих районах Австралии, поэтому предполагается, что речь идет об очень редком виде.
Амебоидный протист
Амебоидный протист (Spiculosiphon oceana) - настоящий гигант среди одноклеточных организмов. Его размеры составляют от 3 до 5 сантиметров.
Поведение этого существа поразило биологов: протист собирает куски губок и строит из них губкообразную оболочку. Более того, оно использует спикулы губок, полностью имитируя их поведение.
Этот удивительный вид был обнаружен в подводной пещере, в 50 км от берега Испании. В той же пещере ранее впервые были обнаружены хищные морские губки.
Микроб стерильных помещений
Этого микроба (Tersicoccus phoenicis) нашли в помещениях, где собираются космические аппараты в условиях (якобы) абсолютной стерильности. Исследователи опасаются, что он уже мог загрязнить Марс, попав на Красную планету вместе с марсоходами. Но не исключено, что его родственники уже обитают на других планетах, поскольку этот организм способен выживать в экстремальных условиях.
Микроб был обнаружен на полу сразу в двух совершенно стерильных помещениях на разных континентах: во Флориде и во Французской Гвиане.
Принимая во внимание меры, предпринимаемые для очистки таких помещений, Tersicoccus phoenicis, по мнению ученых, преподал науке важный урок, в каких невероятных условиях может существовать жизнь.
Муха-фея Динь-Динь
Муха-фея Динь-Динь (Tinkerbella nana), названная в честь крылатой спутницы Питера Пена, обитает в лесах Коста-Рики. Размер ее составляет примерно 0,25 мм, поэтому речь идет об одном из самых мелких насекомых в мире.
Выпуклый земляной слизень
В пещерах западной Хорватии, на глубине более километра, обитает это медленное безглазое существо, выпуклый земляной слизень (Zospeum tholussum). Отсутствие пигментации придает его раковине призрачный вид.
Даже по улиточным стандартам Zospeum tholossum двигается экстремально медленно, преодолевая расстояние менее 2 см в неделю. Ученые считают, что этот миниатюрный организм использует для дальних передвижений потоки воды или же других животных, например, летучих мышей.